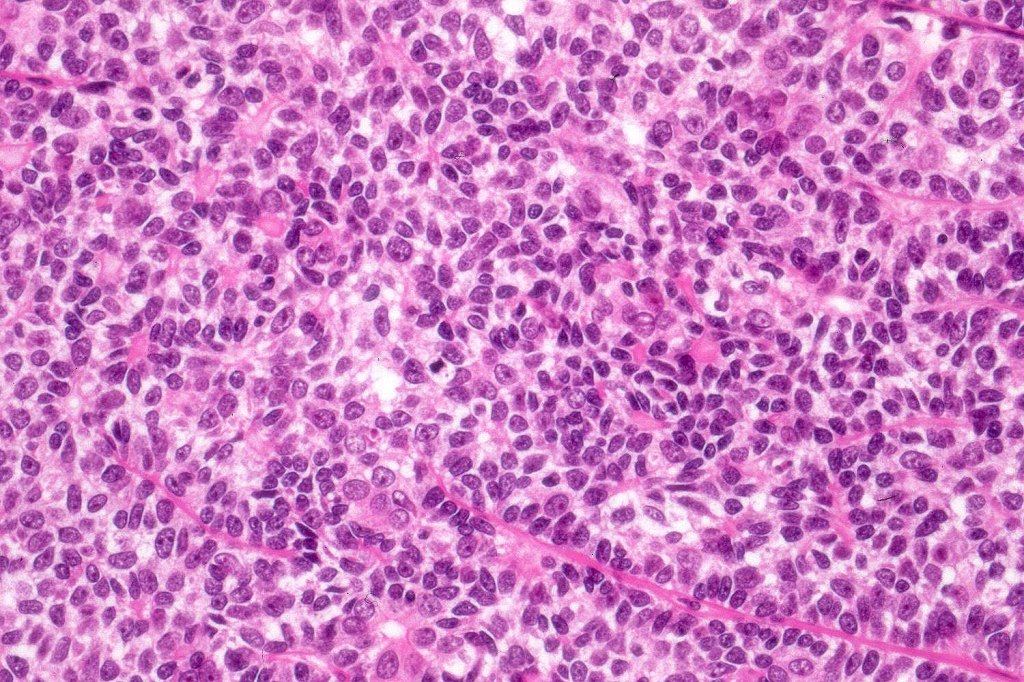
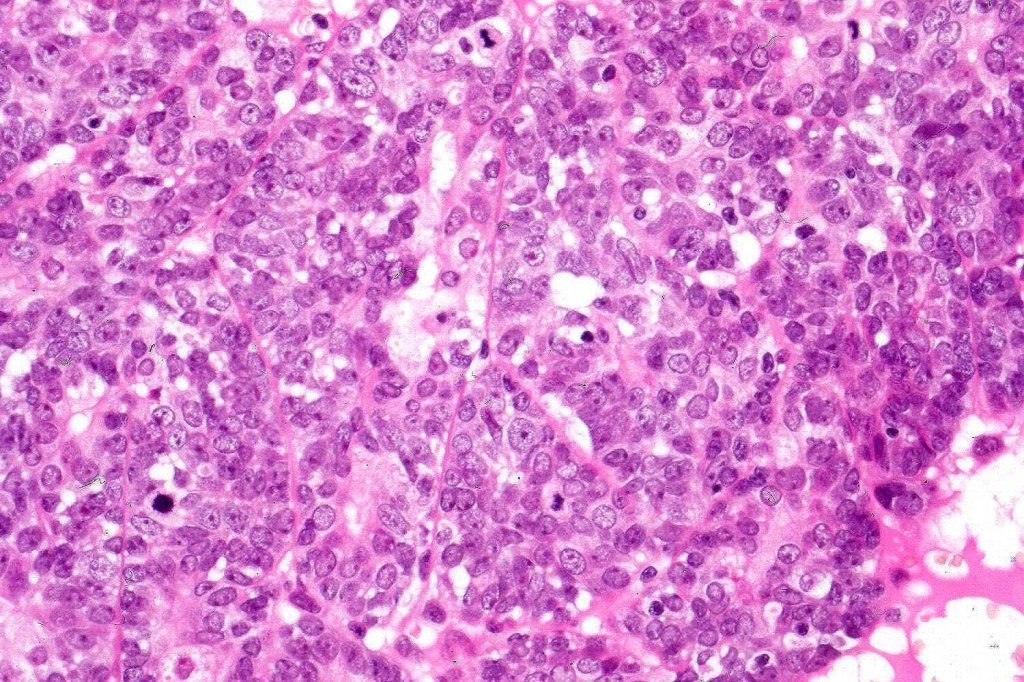
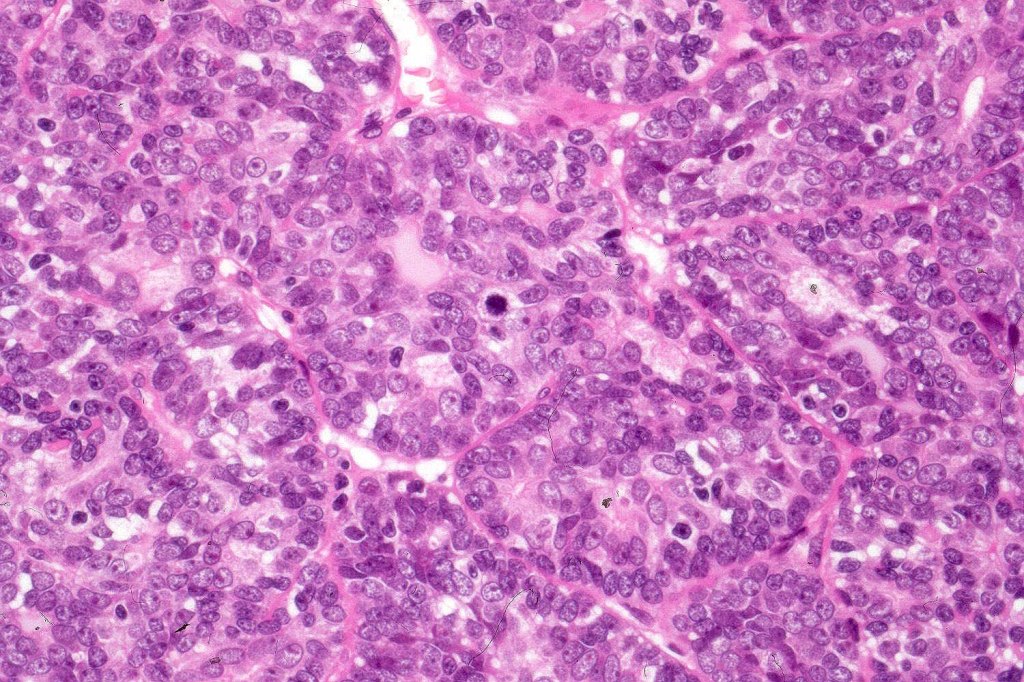
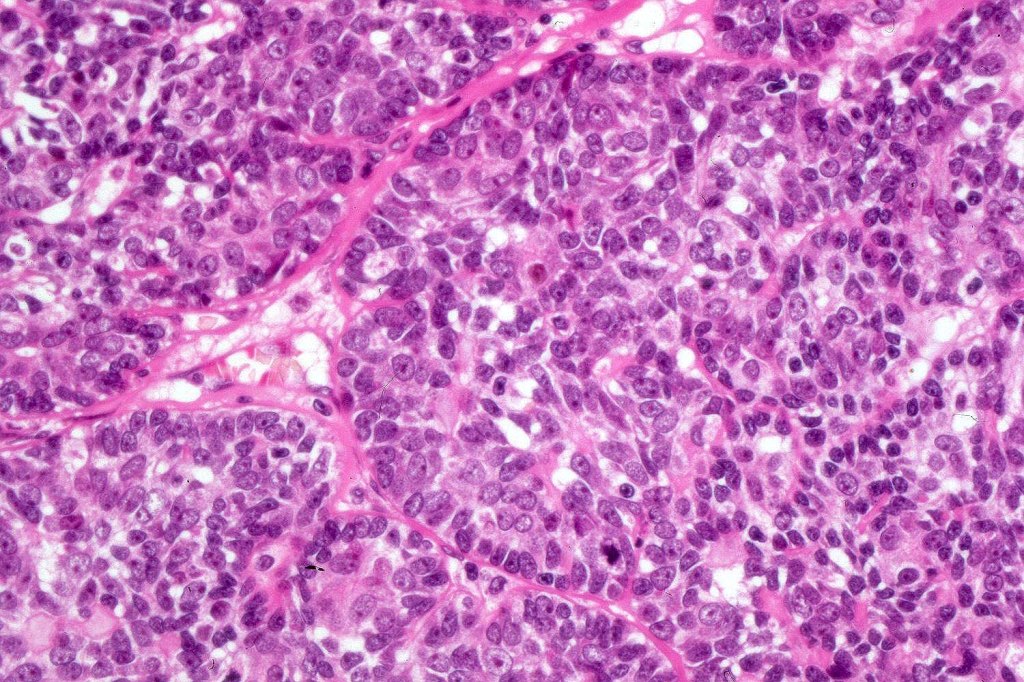

Clinical features
•Extremely rare and arises in a benign precursor tumor
•Possible association with Brooke-Spiegler syndrome
•M=F
•Median age 60 years (range 2-92)
•Limbs>> face, scalp & chest
•Mostly high grade (media survival 10-37%) with metastases to nodes, lung, bone & liver
Histological features
•Pre-existent spiradenoma
•Malignant component shows loss of dual cell population, increased mitotic activity, atypical mitoses & necrosis
•Perineural infiltration & LVI may be present
•Rarely squamous morulae and SCC
•Mixed spiradenocylindrocarcinoma
•Rarely carcinosarcoma has been documented
•Malignant adenomyoepithelioma ex spiradenoma documented (1 case)
•Diagnosis depends on H/E rather than IHC
Classification
•Eccrine spiradenocarcinoma
Sub-classification: Am J Surg Pathology. 2009; 35:705-719
•1. Salivary gland type basal cell adenocarcinoma-like pattern, low grade (BCAC-LG)
•2. Salivary gland type basal cell adenocarcinoma-like pattern, high grade (BCAC-HG)
•3. Invasive adenocarcinoma, not otherwise specified (IAC-NOS)
•4. Spiradenocarcinoma with squamous carcinoma
•5. Spiradenocarcinoma with metaplastic elements (carcinosarcoma)
•I have not found this particularly sub-classification helpful with the exception of the last two categories.
•The alternative classification into low grade (with only mild atypia and increased mitotic activity) and high grade variants has some merit although in any individual case this can be hard to apply unless the whole tumor has been sampled and is of uncertain biological merit.

Leave a comment